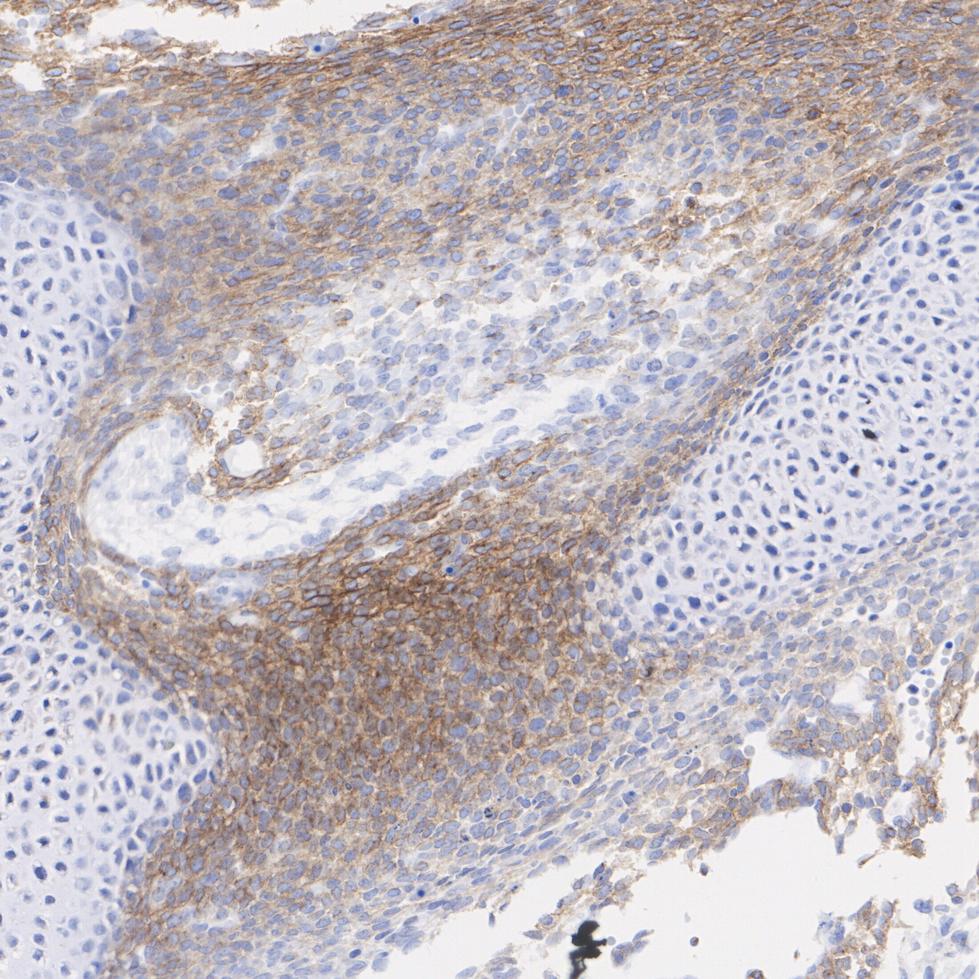
Immunohistochemical analysis of paraffin-embedded rat embryonic femur tissue with Rabbit anti-PDGFR alpha antibody (<a href="/products/ET1702-49" style="font-weight: bold;text-decoration: underline;">ET1702-49</a>) at 1/2,000 dilution.<br /><br />The section was pre-treated using heat mediated antigen retrieval with Tris-EDTA buffer (pH 9.0) for 20 minutes. The tissues were blocked in 1% BSA for 20 minutes at room temperature, washed with ddH<sub>2</sub>O and PBS, and then probed with the primary antibody (<a href="/products/ET1702-49" style="font-weight: bold;text-decoration: underline;">ET1702-49</a>) at 1/2,000 dilution for 1 hour at room temperature. The detection was performed using an HRP conjugated compact polymer system. DAB was used as the chromogen. Tissues were counterstained with hematoxylin and mounted with DPX.

PDGFR alpha Recombinant Rabbit Monoclonal Antibody [JF104-6]
Recombinant Rabbit monoclonal Antibody
Synthetic peptide within C-terminal human PDGFR alpha.
Human, Mouse, Rat (Predicted: Cynomolgus monkey, Pig)
WB, IHC-P, IHC-Fr
Predicted band size: 123 kDa
Mouse embryonic femur tissue, mouse embryonic intervertebral disc tissue, mouse embryonic lung tissue, rat embryonic femur tissue, rat embryonic intervertebral disc tissue, rat embryonic lung tissue, rat endometrium tissue, human colon tissue, human colon cancer tissue, human glioblastoma tissue, NIH/3T3 cell lysates, SHG-44 cell lysates, A549, NIH/3T3.
unconjugated
JF104-6
Liquid
1ug/ul
Store at +4℃ after thawing. Aliquot store at -20℃ or -80℃. Avoid repeated freeze / thaw cycles.
1*TBS (pH7.4), 0.05% BSA, 40% Glycerol. Preservative: 0.05% Sodium Azide.
IgG
Protein A affinity purified.
WB
1:5,000-1:10,000
IHC-P
1:500-1:2,000
IHC-Fr
1:500
| IF | 查看 3 篇文献如下 |
| IHC | 查看 2 篇文献如下 |
| WB | 查看 2 篇文献如下 |
| mIHC | 查看 1 篇文献如下 |
| Human | 查看 3 篇文献如下 |
| Mouse | 查看 2 篇文献如下 |
| Grass carp | 查看 1 篇文献如下 |
| Zebrafish | 查看 1 篇文献如下 |
Platelet-derived growth factor (PDGF) is a mitogen for mesenchyme- and glia-derived cells. PDGF consists of two chains, A and B, which dimerize to form functionally distinct isoforms, PGDF-AA, PDGF-AB and PDGF-BB. These three isoforms bind with different affinities to two receptor types, PDGFR-α and -β, which are endowed with protein tyrosine kinase domains. PDGFR-α can bind to both A and B subunits of PDGF, while PDGFR-β can only bind the B subunit. Ligand binding promotes either homo- or heterodimerization of the PDGF receptors in a specific manner. PDGF-AA induces the dimerization of two α receptors, PDGF-AB induces dimerization of αα and αβ and PDGF-BB induces the formation of three types of dimers, αα, αβ and ββ. Translocation of the PDGFR-β gene with the Tel gene is linked to chronic myelomonocytic leukemia (CMML), a myelodysplastic syndrome, and demonstrates the oncogenic potential of the PDGF receptors.
1. Benedykcinska A et al. Generation of brain tumours in mice by Cre-mediated recombination of neural progenitors in situ with the tamoxifen metabolite endoxifen. Dis Model Mech 9:211-20 (2016).
2. Rondahl V et al. Lrig2-deficient mice are protected against PDGFB-induced glioma. PLoS One 8:e73635 (2013).
Belongs to the protein kinase superfamily. Tyr protein kinase family. CSF-1/PDGF receptor subfamily.
Detected in platelets (at protein level). Widely expressed. Detected in brain, fibroblasts, smooth muscle, heart, and embryo. Expressed in primary and metastatic colon tumors and in normal colon tissue.
N-glycosylated.; Ubiquitinated, leading to its internalization and degradation.; Autophosphorylated on tyrosine residues upon ligand binding. Autophosphorylation occurs in trans, i.e. one subunit of the dimeric receptor phosphorylates tyrosine residues on the other subunit. Phosphorylation at Tyr-731 and Tyr-742 is important for interaction with PIK3R1. Phosphorylation at Tyr-720 and Tyr-754 is important for interaction with PTPN11. Phosphorylation at Tyr-762 is important for interaction with CRK. Phosphorylation at Tyr-572 and Tyr-574 is important for interaction with SRC and SRC family members. Phosphorylation at Tyr-988 and Tyr-1018 is important for interaction with PLCG1.
Golgi apparatus, Cell membrane, cilium.
Alpha-type platelet-derived growth factor receptor antibody
CD140 antigen-like family member A antibody
CD140a antibody
CD140a antigen antibody
MGC74795 antibody
PDGF alpha chain antibody
PDGF-R-alpha antibody
PDGFR 2 antibody
PDGFR alpha antibody
PDGFR2 antibody
展开
Application: IHC-Fr
Species: Mouse
Site: E14.5 embyro
Sample: Frozen section
Antibody concentration: 1:500
Antigen retrieval: Not required

Immunohistochemical analysis of paraffin-embedded mouse embryonic femur tissue with Rabbit anti-PDGFR alpha antibody (ET1702-49) at 1/2,000 dilution.
The section was pre-treated using heat mediated antigen retrieval with Tris-EDTA buffer (pH 9.0) for 20 minutes. The tissues were blocked in 1% BSA for 20 minutes at room temperature, washed with ddH2O and PBS, and then probed with the primary antibody (ET1702-49) at 1/2,000 dilution for 1 hour at room temperature. The detection was performed using an HRP conjugated compact polymer system. DAB was used as the chromogen. Tissues were counterstained with hematoxylin and mounted with DPX.

Immunohistochemical analysis of paraffin-embedded mouse embryonic intervertebral disc tissue with Rabbit anti-PDGFR alpha antibody (ET1702-49) at 1/2,000 dilution.
The section was pre-treated using heat mediated antigen retrieval with Tris-EDTA buffer (pH 9.0) for 20 minutes. The tissues were blocked in 1% BSA for 20 minutes at room temperature, washed with ddH2O and PBS, and then probed with the primary antibody (ET1702-49) at 1/2,000 dilution for 1 hour at room temperature. The detection was performed using an HRP conjugated compact polymer system. DAB was used as the chromogen. Tissues were counterstained with hematoxylin and mounted with DPX.

Immunohistochemical analysis of paraffin-embedded mouse embryonic lung tissue with Rabbit anti-PDGFR alpha antibody (ET1702-49) at 1/2,000 dilution.
The section was pre-treated using heat mediated antigen retrieval with Tris-EDTA buffer (pH 9.0) for 20 minutes. The tissues were blocked in 1% BSA for 20 minutes at room temperature, washed with ddH2O and PBS, and then probed with the primary antibody (ET1702-49) at 1/2,000 dilution for 1 hour at room temperature. The detection was performed using an HRP conjugated compact polymer system. DAB was used as the chromogen. Tissues were counterstained with hematoxylin and mounted with DPX.
Immunohistochemical analysis of paraffin-embedded rat embryonic femur tissue with Rabbit anti-PDGFR alpha antibody (ET1702-49) at 1/2,000 dilution.
The section was pre-treated using heat mediated antigen retrieval with Tris-EDTA buffer (pH 9.0) for 20 minutes. The tissues were blocked in 1% BSA for 20 minutes at room temperature, washed with ddH2O and PBS, and then probed with the primary antibody (ET1702-49) at 1/2,000 dilution for 1 hour at room temperature. The detection was performed using an HRP conjugated compact polymer system. DAB was used as the chromogen. Tissues were counterstained with hematoxylin and mounted with DPX.

Immunohistochemical analysis of paraffin-embedded rat embryonic intervertebral disc tissue with Rabbit anti-PDGFR alpha antibody (ET1702-49) at 1/500 dilution.
The section was pre-treated using heat mediated antigen retrieval with Tris-EDTA buffer (pH 9.0) for 20 minutes. The tissues were blocked in 1% BSA for 20 minutes at room temperature, washed with ddH2O and PBS, and then probed with the primary antibody (ET1702-49) at 1/500 dilution for 1 hour at room temperature. The detection was performed using an HRP conjugated compact polymer system. DAB was used as the chromogen. Tissues were counterstained with hematoxylin and mounted with DPX.

Immunohistochemical analysis of paraffin-embedded rat embryonic lung tissue with Rabbit anti-PDGFR alpha antibody (ET1702-49) at 1/2,000 dilution.
The section was pre-treated using heat mediated antigen retrieval with Tris-EDTA buffer (pH 9.0) for 20 minutes. The tissues were blocked in 1% BSA for 20 minutes at room temperature, washed with ddH2O and PBS, and then probed with the primary antibody (ET1702-49) at 1/2,000 dilution for 1 hour at room temperature. The detection was performed using an HRP conjugated compact polymer system. DAB was used as the chromogen. Tissues were counterstained with hematoxylin and mounted with DPX.

Immunohistochemical analysis of paraffin-embedded rat endometrium tissue with Rabbit anti-PDGFR alpha antibody (ET1702-49) at 1/1,000 dilution.
The section was pre-treated using heat mediated antigen retrieval with Tris-EDTA buffer (pH 9.0) for 20 minutes. The tissues were blocked in 1% BSA for 20 minutes at room temperature, washed with ddH2O and PBS, and then probed with the primary antibody (ET1702-49) at 1/1,000 dilution for 1 hour at room temperature. The detection was performed using an HRP conjugated compact polymer system. DAB was used as the chromogen. Tissues were counterstained with hematoxylin and mounted with DPX.

Immunohistochemical analysis of paraffin-embedded human colon tissue with Rabbit anti-PDGFR alpha antibody (ET1702-49) at 1/500 dilution.
The section was pre-treated using heat mediated antigen retrieval with Tris-EDTA buffer (pH 9.0) for 20 minutes. The tissues were blocked in 1% BSA for 20 minutes at room temperature, washed with ddH2O and PBS, and then probed with the primary antibody (ET1702-49) at 1/500 dilution for 1 hour at room temperature. The detection was performed using an HRP conjugated compact polymer system. DAB was used as the chromogen. Tissues were counterstained with hematoxylin and mounted with DPX.

Immunohistochemical analysis of paraffin-embedded human colon cancer tissue with Rabbit anti-PDGFR alpha antibody (ET1702-49) at 1/500 dilution.
The section was pre-treated using heat mediated antigen retrieval with Tris-EDTA buffer (pH 9.0) for 20 minutes. The tissues were blocked in 1% BSA for 20 minutes at room temperature, washed with ddH2O and PBS, and then probed with the primary antibody (ET1702-49) at 1/500 dilution for 1 hour at room temperature. The detection was performed using an HRP conjugated compact polymer system. DAB was used as the chromogen. Tissues were counterstained with hematoxylin and mounted with DPX.

Immunohistochemical analysis of paraffin-embedded human glioblastoma tissue with Rabbit anti-PDGFR alpha antibody (ET1702-49) at 1/500 dilution.
The section was pre-treated using heat mediated antigen retrieval with Tris-EDTA buffer (pH 9.0) for 20 minutes. The tissues were blocked in 1% BSA for 20 minutes at room temperature, washed with ddH2O and PBS, and then probed with the primary antibody (ET1702-49) at 1/500 dilution for 1 hour at room temperature. The detection was performed using an HRP conjugated compact polymer system. DAB was used as the chromogen. Tissues were counterstained with hematoxylin and mounted with DPX.

Western blot analysis of PDGFR alpha on NIH/3T3 cell lysates with Rabbit anti-PDGFR alpha antibody (ET1702-49) at 1/5,000 dilution.
Lysates/proteins at 10 µg/Lane.
Predicted band size: 123 kDa
Observed band size: 180 kDa
Exposure time: 2 minutes;
6% SDS-PAGE gel.
Proteins were transferred to a PVDF membrane and blocked with 5% NFDM/TBST for 1 hour at room temperature. The primary antibody (ET1702-49) at 1/5,000 dilution was used in 5% NFDM/TBST at room temperature for 2 hours. Goat Anti-Rabbit IgG - HRP Secondary Antibody (HA1001) at 1/50,000 dilution was used for 1 hour at room temperature.

☑ Knockdown (KD)
Western blot analysis of PDGFR alpha on different lysates with Rabbit anti-PDGFR alpha antibody (ET1702-49) at 1/5,000 dilution.
Lane 1: NIH/3T3-si NT cell lysate
Lane 2: NIH/3T3-si PDGFR alpha cell lysate
Lysates/proteins at 10 µg/Lane.
Predicted band size: 123 kDa
Observed band size: 190 kDa
Exposure time: 2 minutes;
4-20% SDS-PAGE gel.
Proteins were transferred to a PVDF membrane and blocked with 5% NFDM in TBST for 1 hour at room temperature. The primary antibody (ET1702-49, 1/5,000) and Loading control antibody (Rabbit anti-GAPDH, ET1601-4, 1/10,000) were used in 5% BSA at room temperature for 2 hours. Goat Anti-rabbit IgG-HRP Secondary Antibody (HA1001) at 1/50,000 dilution was used for 1 hour at room temperature.
PPY-Induced iCAFs Cultivate an Immunosuppressive Microenvironment in Pancreatic Cancer
Author: Mengdie Cao, Wang Peng, Bin Cheng, Ronghua Wang, Wei Chen, Luyao Liu, Hai Huang, Shiru Chen, Haochen Cui, JingWen Liang, Qiaodan Zhou, Si Xiong, Shuya Bai, Luoxia Liu, Yuchong Zhao
PMID: 40162859
期刊: Advanced Science
应用: mIHC
反应种属:
发表时间: 2025 Mar
Copyright © 广州杰特伟生物科技有限公司 All Rights Reserved. 备案号:粤ICP备19077843号